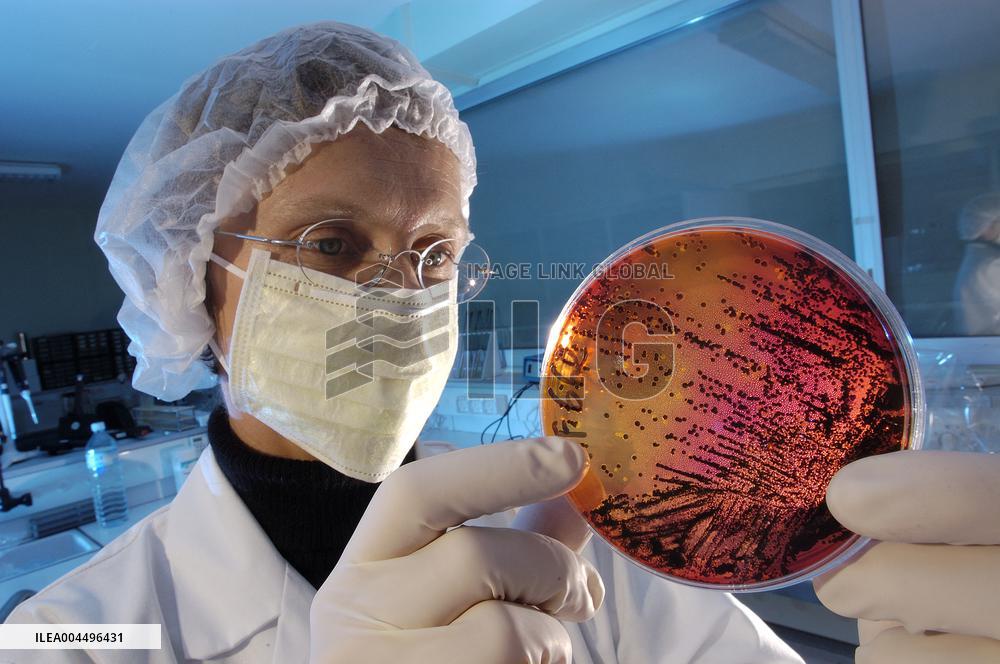
Illustration - Economy

Illustration - Economy
FRANCE. BRITTANY REGION. COTES D'ARMOR (22) PLOUFRAGAN. THE LABORATORIES OF AFSSA (FRENCH FOOD AND HEALTH AGENCY). A TECHNICIAN EXAMINES BACTERIAL CULTURE IN A PETRI DISH Photo by Christophe Lepetit/Only France/ABACAPRESS.COM
- Product Code
- ILEA004496431
- Registered date
- 2015/7/15 00:00:00
- Credit
- Abaca Press / Kyodo News Images
- Media source
- Lepetit Christophe/Only FranceABACA
- Media size
- 5000 × 3324 pixel
- Resolution
- 72 dpi
- Deployment size
- 3.64(MB)*
- Special instruction
*File size when opened in Photoshop, etc.









